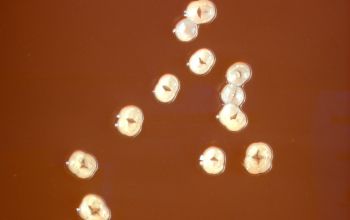

Actinomyces graevenitzii
-
General information
Actinomyces graevenitzii is a newly recognized Actinomyces species that is seldom isolated from clinical specimens.
This organism is an opportunistic human pathogen.
Taxonomy
Family: Actinomycetaceae
Natural habitats
It is possible a component of the oral pharyngeal flora.
Very little is known about the clinical features and pathogenesis
Clinical significance
A. graevenitzii is believed to be associated with classic actinomycosis.
Isolated from human clinical specimens, mainly respiratory tract secretions.
-
Gram stain
Gram positive thick, granular rods
of medium length, and branched.
-
Culture characteristics
-
Facultative anaerobic
5 % CO2 improves the growth
BA: colonies are white, pronounced molar tooth or smooth and convex.
They are small, 0.2 mm after 24 hours of incubation.
The rough and smooth forms occur together.
The colonies adhere very strongly to the agar surface.
The adherence become less after repeated subculturing.
Old colonies can be dark brown.
Colonies are fluorescent red under the Wood's Lamp
(Actinomyces selective agar with metronidazole 10 mg/l and nalidixic acid 30 mg/l))
BBAØ: growth
-
-
Characteristics
-
References
James Versalovic et al.(2011) Manual of Clinical Microbiology 10th Edition
Karen C. Carrol et al (2019) Manual of Clinical Microbiology, 12th Edition